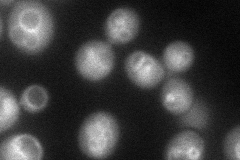
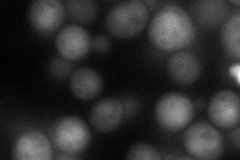
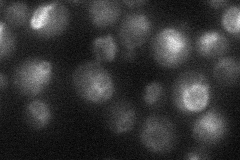

View description
Putative GTP binding protein that negatively regulates Ran/Tc4 GTPase cycle; activates transcription; subunit of EGO and GSE complexes; required for sorting of Gap1p; localizes to cytoplasm and to chromatin; homolog of human RagC and RagD
Localization:
Intensity:
Fold change:
Significance:
-
C’ GFP library in SD

vacuole membrane30.67 -
N' NOP1pr-GFP in SD
vacuole membrane64.8938 -
N' TEF2pr-mCherry in SD
cytosol,vacuole membrane80.6834 -
N' NATIVEpr-GFP in SD
vacuole membrane34.3189 -
N' TEF2pr-VC and Cyto-VN in SD

below threshold27.2887 -
C’ GFP library in SD+DTT

vacuole membrane36.81.19No -
C’ GFP library in SD+H2O2

vacuole membrane35.651.16No -
C’ GFP library in Starvation Media

vacuole membrane60.811.98Yes -
C’ GFP library on the background of Pup2-DaMP

vacuole membrane -
C’ GFP library on the background of CCT mutant

vacuole membrane42.77011.39438Yes
